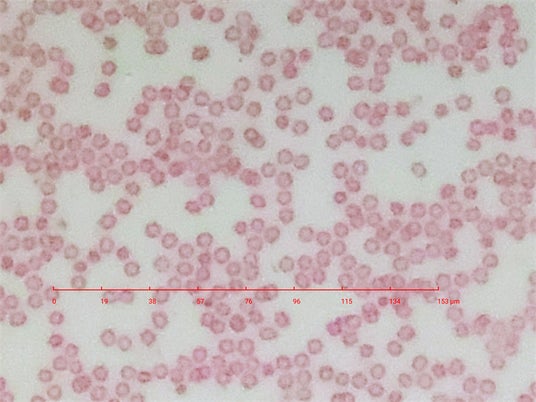

ミクロの世界を身近にする指先サイズの高倍率顕微鏡レンズ、「ミクロハンターMH-X250」の一般販売開始のお知らせ
合同会社KaraSeed
スマートフォンで本格的な顕微鏡観察が可能な「ミクロハンターMH-X250」の一般販売を開始いたします。

販売サイト(公式ショップ):https://bit.ly/4k6x2vt
「ミクロハンターMH-X250」は、スマートフォンにピタッと装着するだけで高倍率・高精細な顕微鏡観察が可能になる新世代の顕微鏡レンズです。
指先サイズながら、光学250倍の倍率を実現し(スマホ機能を活用すれば最大1200倍)、科学教育や研究、クリエイティブな用途など幅広く活用できます。
観察の視点が変わる。世界が広がる。
過去のレンズシリーズの購入者様からは、『今まで見えていた世界はほんの数パーセントだったと感動しました』といった喜びの声が寄せられています。

ユリの花粉を観察する様子
最新レンズの「ミクロハンターMH-X250」は、今年1月下旬にクラウドファンディングでの先行販売&配送を終え、多くの支援者の皆様からご好評をいただきました。そして今回、一般販売を開始することで、より多くの方々に「ミクロの世界の面白さ」を体験していただく機会を提供します。

ツユクサの気孔の染色標本
人の血球の染色標本

最大0.75μmの解像度を実現
想像力を刺激する新しいツール
「ミクロハンターMH-X250」は、単なる観察ツールではなく、創造力をかき立てるデバイスです。
ミクロという新しい視点で世界を切り取る事で、アーティストはミクロの世界をインスピレーションとして活用可能。

ハエの複眼
また、家庭や教育現場では、お子さんや学生が実際にミクロの世界を体験することで、科学への興味を深めるきっかけになります。
「小さなものを大きく見ることで、新たな発見が生まれる。」
そんな体験を、誰もが簡単にできるようになるのが「ミクロハンターMH-X250」です。
「最高の発明品」として米国大手ニュース誌に取り上げられたレンズシリーズの最新作
「ミクロハンターMH-X250」は、米国大手ニュース誌のTIMEに2022年に「最高の発明品」として取り上げられた「ミクロハンターMH-X30」に続く最新の顕微鏡レンズで、シリーズ史上最大倍率を誇ります(250~1200倍)。

現在は公式ショップにて4種類のレンズを販売中

ミクロハンターキットMH-X250にはフォーカススタンドも付属
「ミクロハンターMH-X250」の主な特徴

・250倍の高倍率:微細な構造までクリアに観察可能。
・スマホ対応:iPhone・Androidの両方で使用可能。
・コンパクト設計:持ち運びやすく、どこでも観察が可能。
・高精細レンズ搭載:科学教育や研究用途にも適した高品質な光学設計。
・動画・写真撮影機能:スマホで簡単にミクロの世界を記録。
価格と購入方法
「ミクロハンターMH-X250」は、ミクロハンター公式ショップにて販売中です。
【ミクロハンター公式ショップ】
https://bit.ly/4k6x2vt
価格:6,980円(税込)
「身の回りの世界を、これまでにない視点で観察し、新しい発見をする楽しさを多くの人に届けたい。」
そんな想いを込めて、ついに一般販売を開始いたしました。
ぜひ、この機会に「ミクロハンターMH-X250」で、新しい視点の世界を体験してください。
【製品公式ページ】
https://microhunter.karaseed.com/mh-x250/
【会社概要】
会社名:合同会社KaraSeed
所在地:東京都府中市白糸台4-2-8
設立:2020年1月7日
事業内容:各種商品の販売、製造、輸入
【お客様からのお問い合わせ先】
microHunter事務局
お問い合わせフォーム:https://microhunter.shop/pages/contact






















